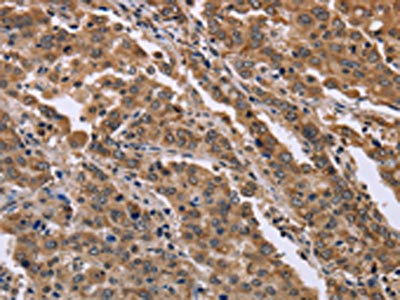

FAM3B Antibody
-
中文名稱:FAM3B兔多克隆抗體
-
貨號:CSB-PA828051
-
規格:¥1100
-
圖片:
-
其他:
產品詳情
-
Uniprot No.:
-
基因名:
-
別名:2-21 antibody; C21orf11 antibody; C21orf76 antibody; Cytokine like protein 2 21 antibody; Cytokine-like protein 2-21 antibody; Fam3b antibody; FAM3B_HUMAN antibody; Family with sequence similarity 3 member B antibody; ORF9 antibody; Pancreatic-derived factor antibody; PANDER antibody; PRED44 antibody; Protein FAM3B antibody
-
宿主:Rabbit
-
反應種屬:Human,Mouse
-
免疫原:Fusion protein of Human FAM3B
-
免疫原種屬:Homo sapiens (Human)
-
標記方式:Non-conjugated
-
抗體亞型:IgG
-
純化方式:Antigen affinity purification
-
濃度:It differs from different batches. Please contact us to confirm it.
-
保存緩沖液:-20°C, pH7.4 PBS, 0.05% NaN3, 40% Glycerol
-
產品提供形式:Liquid
-
應用范圍:ELISA,IHC
-
推薦稀釋比:
Application Recommended Dilution ELISA 1:2000-1:5000 IHC 1:50-1:200 -
Protocols:
-
儲存條件:Upon receipt, store at -20°C or -80°C. Avoid repeated freeze.
-
貨期:Basically, we can dispatch the products out in 1-3 working days after receiving your orders. Delivery time maybe differs from different purchasing way or location, please kindly consult your local distributors for specific delivery time.
-
用途:For Research Use Only. Not for use in diagnostic or therapeutic procedures.
相關產品
靶點詳情
-
功能:Induces apoptosis of alpha and beta cells in a dose- and time-dependent manner.
-
基因功能參考文獻:
- Taken together, by activating pro-survival mechanisms FAM3B overexpression contributes to increased resistance to cell death and tumor growth in nude mice, highlighting a putative role for this cytokine in prostate cancer progression. PMID: 29357840
- FAM3B overexpression contributes to increased resistance to cell death and tumor growth in nude mice. PMID: 29357840
- Data suggest that serum PANDER levels are significantly elevated in patients with long-standing type 2 diabetes as compared to patients with recently diagnosed type 2 diabetes and control subjects; serum PANDER levels vary according to degree of insulin resistance. PMID: 28161382
- Circulating level of pancreatic-derived factor (PANDER) in relation to the accumulation in metabolic syndrome suggested that persons with elevated levels of PANDER were associated with an increased risk of metabolic syndrome. PMID: 27181109
- in-vitro and in-vivo glucose is a potent stimulator of the PANDER promoter within the liver and this response may be facilitated by ChREBP. PMID: 26123584
- beta-cell-secreted PANDER regulated the hepatic insulin and lipogenenic signaling and impact overall glycemia. PMID: 24468680
- It is an important regulator of glucose and lipid metabolism and plays a role in the pathogenesis of nonalcoholic fatty liver disease.(review) PMID: 23855304
- our studies demonstrated that silencing FAM3B promoted p53 phosphorylation and induced p53 accumulation by decreasing Mdm2 expression, which resulted in apoptotic cell death. PMID: 23246487
- These results suggest that FAM3B-258 promotes colon cancer cell invasion and metastasis through upregulation of Slug. PMID: 23059759
- Localized to the islets of Langerhans. PMID: 12160727
- Helices B and C and the second disulfide bond of PANDER are essential for PANDER-induced beta-cell death. PMID: 16114871
- PANDER is secreted from 2 types of pancreatic cells, glucose stimulates its secretion in beta cell and primary islets but not in alpha-cells, it is likely cosecreted with insulin, and structure and conformation is vital for PANDER secretion. PMID: 16249448
顯示更多
收起更多
-
亞細胞定位:Secreted. Note=Present in insulin secretory granules and likely cosecreted with insulin. Localized in discrete vesicular and perinuclear structure.
-
蛋白家族:FAM3 family
-
組織特異性:Highly expressed in the pancreas. Also found in the colon, kidney, prostate, small intestine and testis.
-
數據庫鏈接:
Most popular with customers
-
-
YWHAB Recombinant Monoclonal Antibody
Applications: ELISA, WB, IHC, IF, FC
Species Reactivity: Human, Mouse, Rat
-
Phospho-YAP1 (S127) Recombinant Monoclonal Antibody
Applications: ELISA, WB, IHC
Species Reactivity: Human
-
-
-
-
-